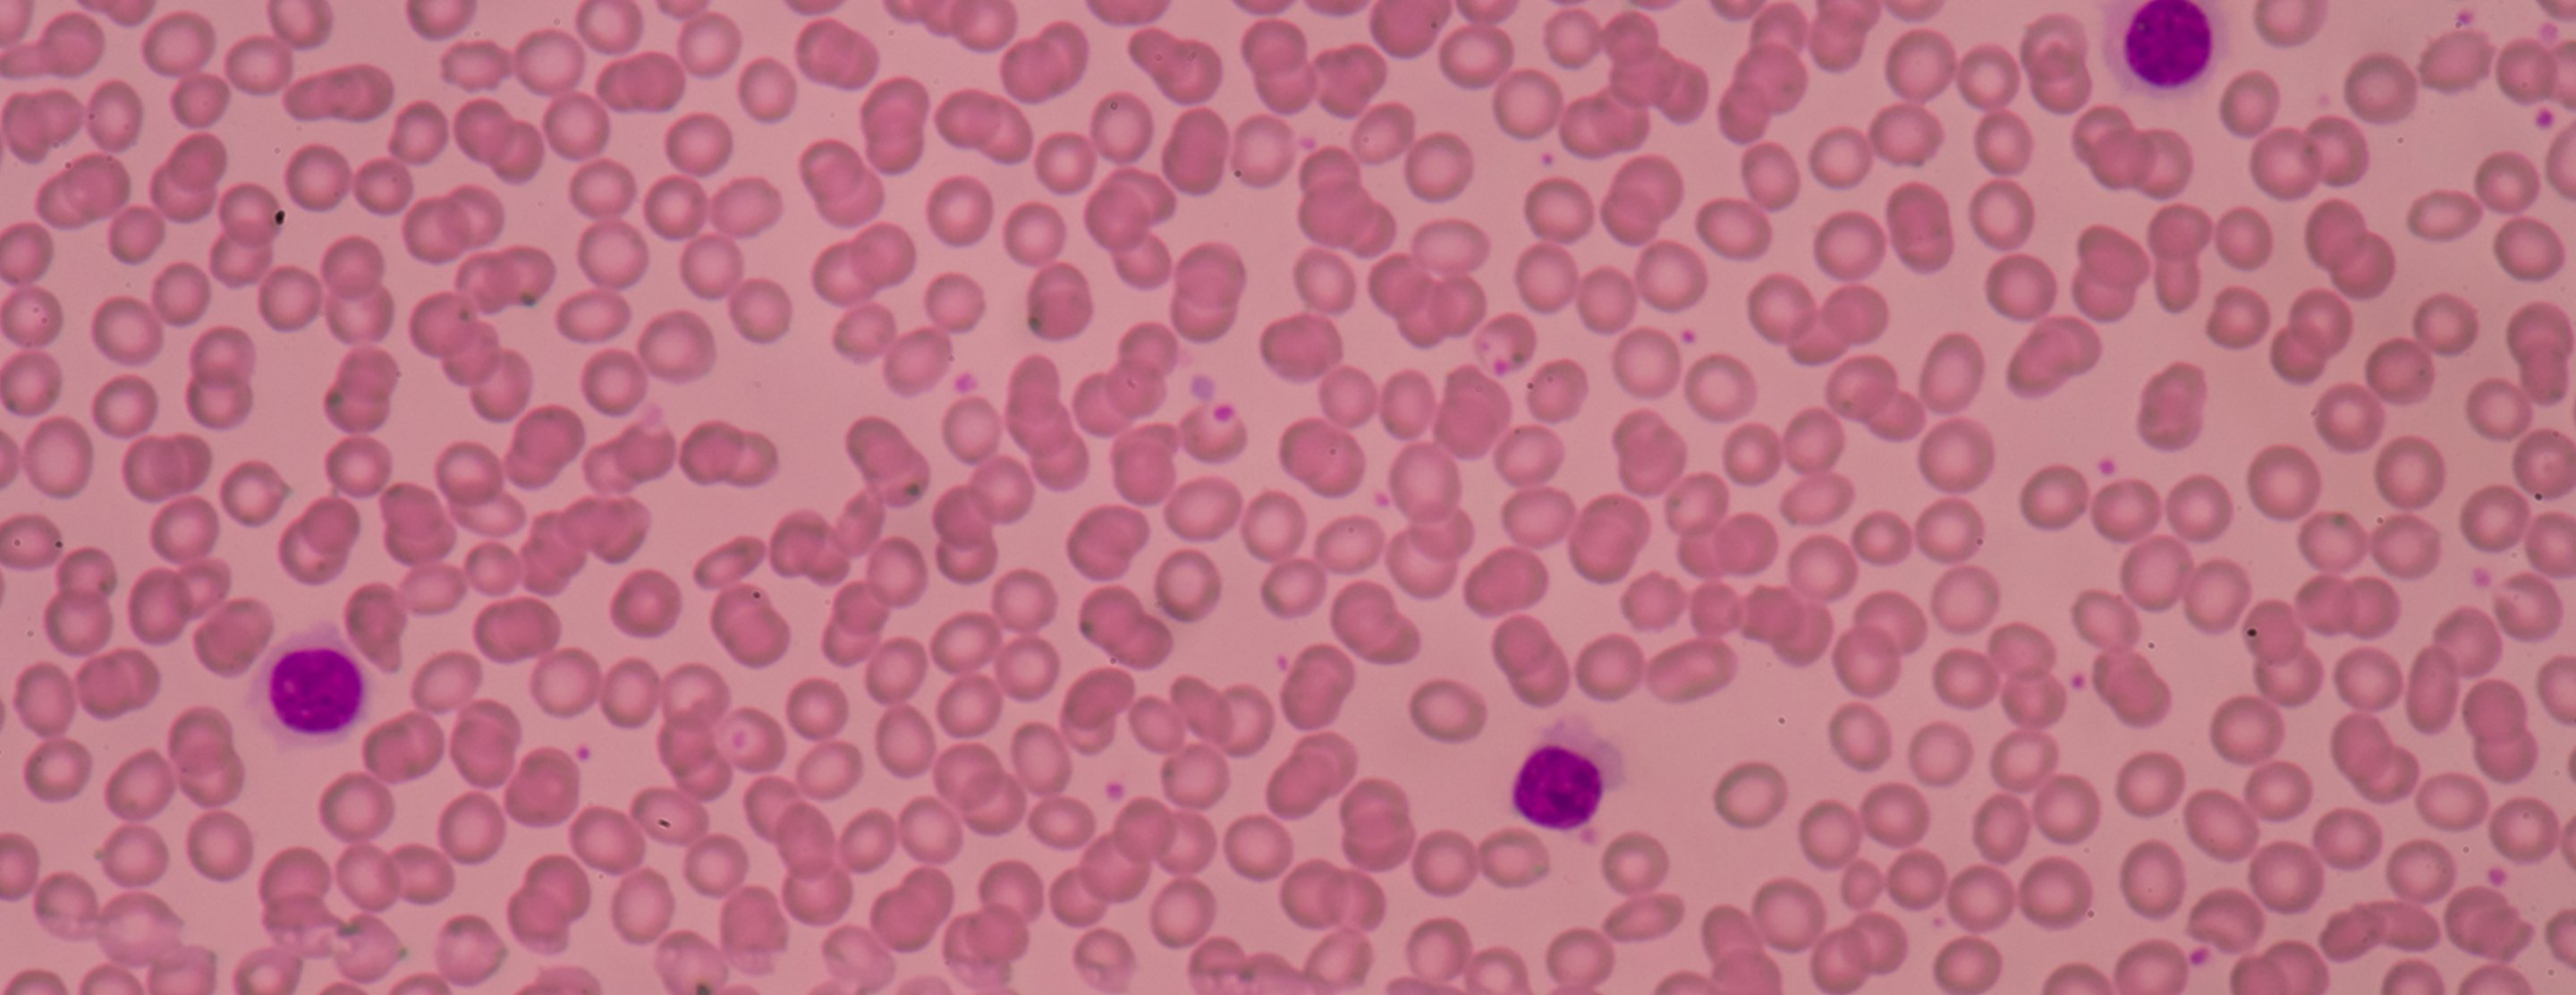

Overview
A bone marrow transplant (also called a stem cell transplant) replaces diseased or damaged stem cells with healthy ones. Stem cells develop into the various blood cells your body needs: red blood cells, which carry oxygen; white blood cells, which fight infection; and platelets, which clump together to form clots when you're bleeding.
Stem cells are produced in bone marrow (the spongy tissue inside bones), but also can be stimulated to travel into the bloodstream with the use of growth factors (proteins that regulate cell processes). When stem cells are collected from bone marrow (either the patient's own or that of a matched donor), the procedure is called a bone marrow transplant. When stem cells are collected from the bloodstream, the procedure is called a peripheral stem cell transplant.
Transplants have successfully treated blood cancers, including leukemia, lymphoma, multiple myeloma and myelodysplastic syndromes, as well as certain solid tumors, such as testicular cancer or breast cancer. They've also been used as a therapy for disorders associated with bone marrow failure, such as aplastic anemia.
Evaluation for a transplant
During your first visit to the Bone Marrow Transplant, Cell and Gene Therapy Program, you'll be assigned to a transplantation specialist, who will evaluate whether a stem cell transplant is appropriate for you. The doctor will review your medical record and history, perform a physical exam and possibly order additional tests. If the doctor determines you're a good candidate, they will recommend a treatment plan, including the type of transplant you should have.
Types of transplants
There are two main transplant categories:
- Autologous transplants. The bone marrow or stem cells come from the patient.
- Allogeneic transplants. The bone marrow or stem cells come from a matched donor, who may be related to the patient.
See our pages on each type for more information on transplant preparation, the procedure itself and post-transplant care.